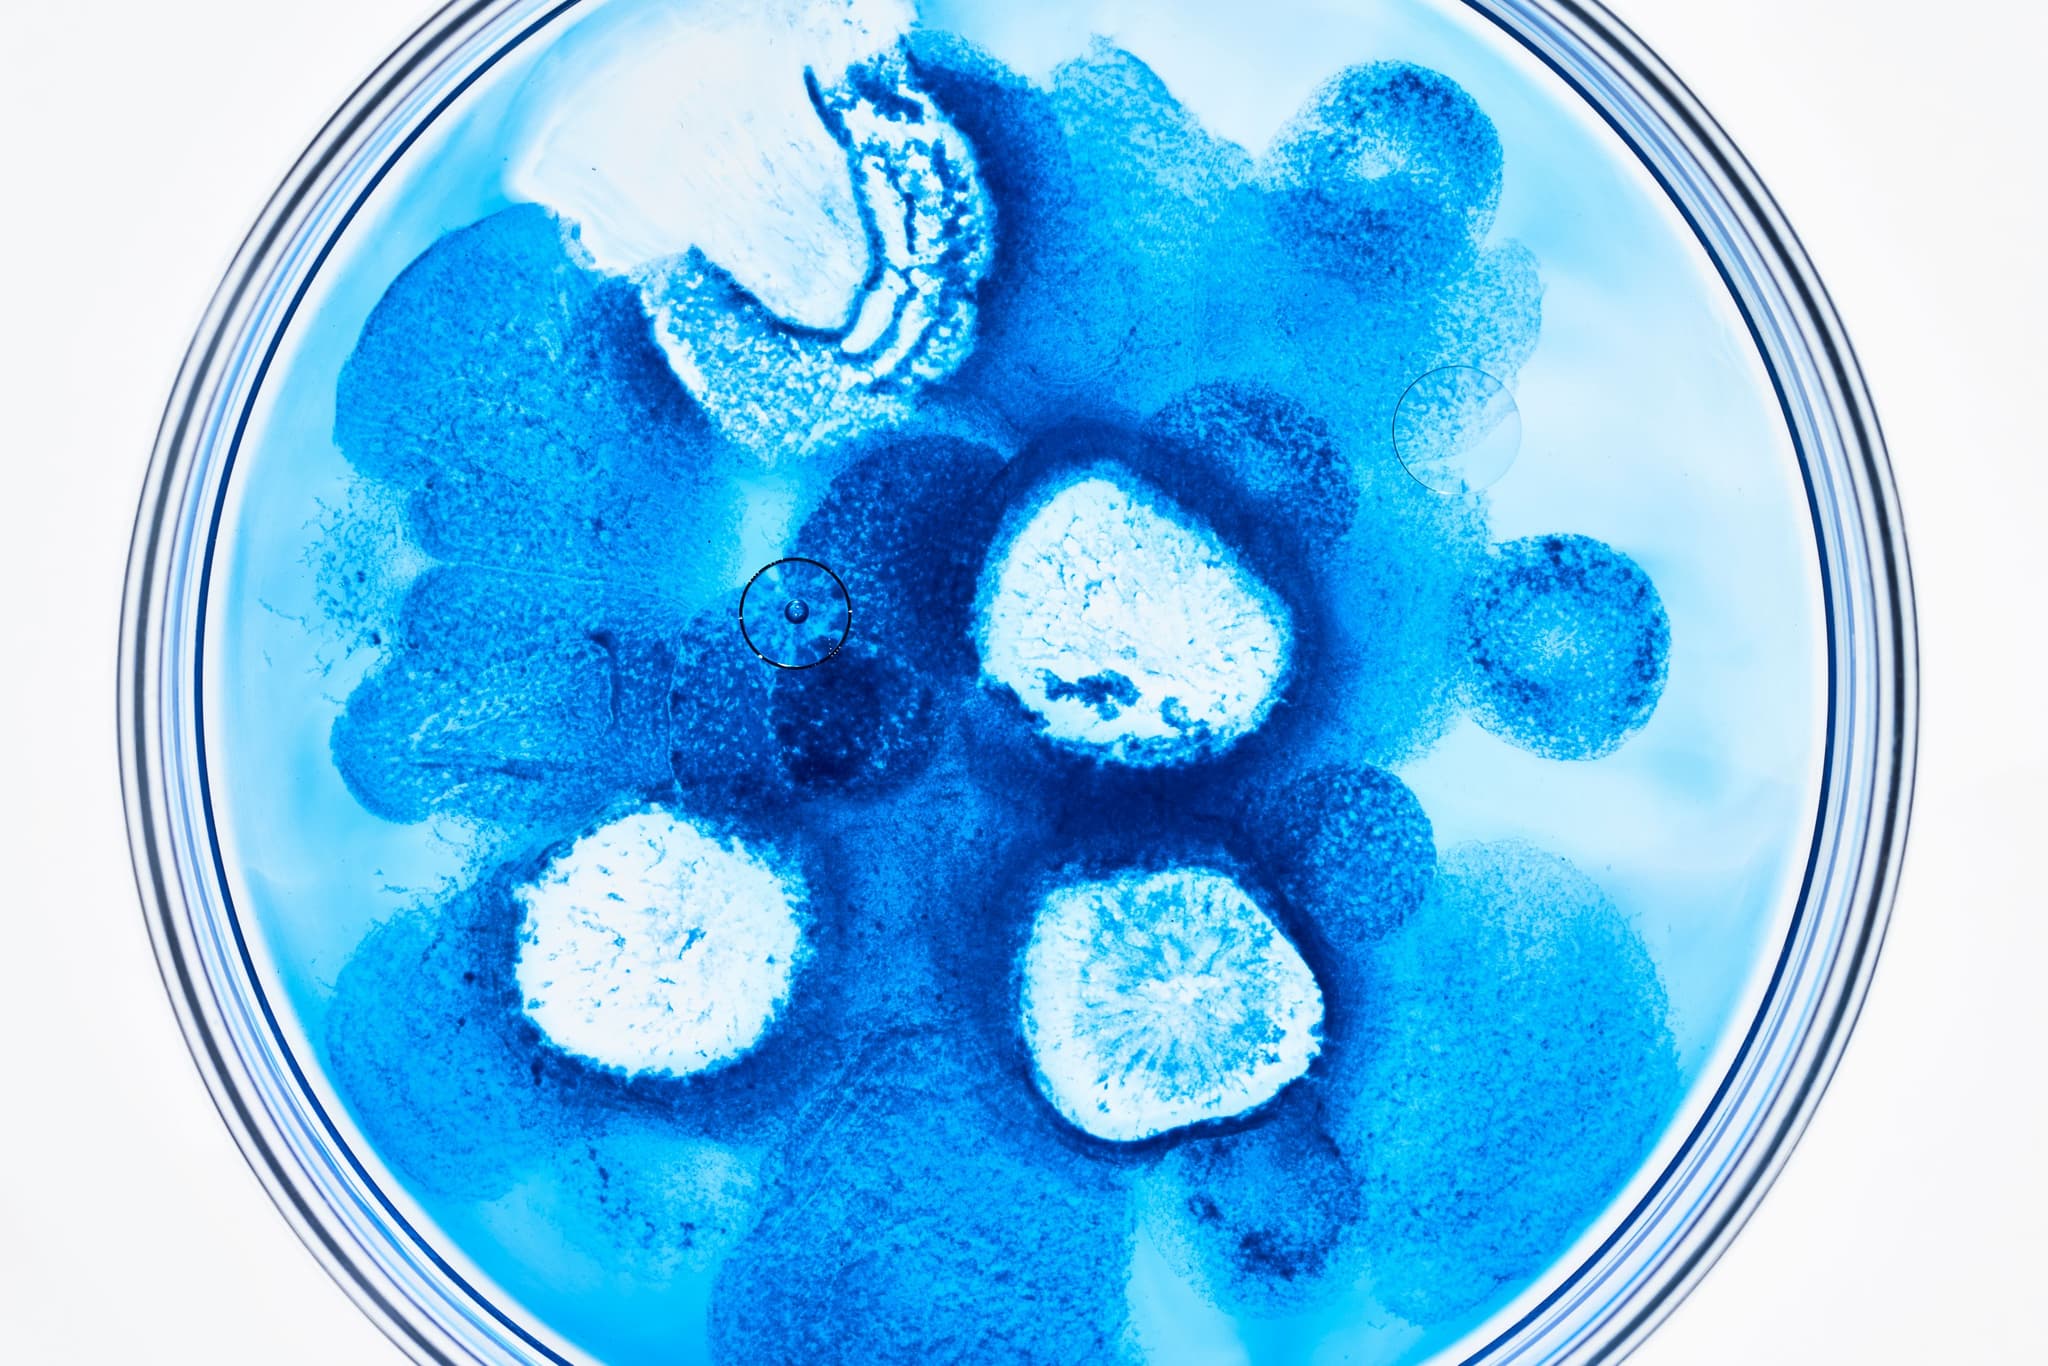
Photo courtesy of Algaeing.

How are algae materials derived for Algadye™ and Algaink™, and how do these processes differ from conventional plant-based dye extraction? What environmental and scalability advantages does algae offer?
Algadye™ and Algaink™ are fully commercial, algae-powered colors. Algaeing uses a proprietary process to create our colors while preserving the benefits of algae.
Microalgae are single-cell organisms that naturally absorb carbon dioxide (CO₂) and release oxygen through photosynthesis. Unlike terrestrial plants, which allocate energy to growing leaves, stems, and branches, every part of a microalga is dedicated to carbon capture and useful biomaterial production. This efficiency translates into tangible benefits.
We partner with sustainable algae growers who cultivate microalgae in controlled, closed-loop systems that use significantly less water than traditional plant-based dye sources. Additionally, algae thrive in environments unsuitable for traditional agriculture, reducing pressure on arable land. Since algae can be cultivated near production facilities, transportation-related emissions are minimized, enhancing supply chain efficiency.
From a scalability perspective, microalgae grow much faster than terrestrial plants and can be cultivated year-round. This continuous production ensures a stable, renewable supply, enabling us to deliver consistent, algae-powered colors season after season.

Your products claim a 98% reduction in water use and a 70-74% reduction in greenhouse gas emissions compared to conventional dyes. Can you outline the methodologies, frameworks or standards, used to measure and validate these environmental savings?
Our products reduce water usage by 98% and cut greenhouse gas (GHG) emissions by 70–74% compared to conventional dye and ink production. These game-changing environmental savings have been independently verified by Made2Flow, a leading third-party assessor.
By using renewable feedstocks instead of petroleum-based alternatives, we not only reduce land use but also drive a fundamental shift toward more sustainable production. Additionally, our process operates at cooler temperatures, significantly lowering energy consumption and reducing dependence on fossil fuels.

Algadye™ and Algaink™ are described as exceeding traditional fastness standards. Could you detail the specific testing protocols and parameters (e.g., ISO standards) for light, washing, rubbing, and water fastness, and explain how these compare to conventional "non-clean" dyes?
Our ready-to-use clean colors perform just like conventional dyes—without the toxic chemicals or negative environmental impact. Coming from the industry, we design our innovations for scale.
To ensure our products make the greatest impact and integrate seamlessly into brands and manufacturers worldwide, we subject them to the textile industry’s most rigorous performance tests. Conducted in internationally recognized laboratories and according to established standards, these tests assess light fastness, color fastness to washing, color fastness to water, color fastness to rubbing, and fabric appearance after washing.


Are there specific substrates or materials where Algadye™ and Algaink™ face challenges in application? What modifications or adjustments are required for such materials to ensure successful implementation?
Our colors are drop-in and ready to use within existing manufacturing processes—no capital investment or adjustments required.
When it comes to substrates and materials, we also offer custom solutions tailored to client needs. Our team of in-house scientists, algae specialists, chemists, and biologists continuously push the boundaries of innovation, expanding the possibilities for applying healthy, algae-powered colors across various materials.

What is your current production capacity, and what strategies or technological adaptations do you have in place—or would require—to scale up while ensuring seamless integration with existing industrial dyeing and printing systems without additional capital investment?
Our state-of-the-art technology is designed for seamless integration with existing industrial dyeing and printing systems—no additional capital investment or learning curve required.
Our colors are fully commercial, scalable, and ready for immediate implementation. We are already operating at an industrial scale, and with new strategic partnerships in 2025, we’re set to expand even further, tripling production to meet growing global demand.

With 15 colors for Algadye™ and 19 for Algaink™, how does your R&D process support the development of new shades while adhering to sustainability metrics? Are there limitations in replicating specific hues or achieving certain pigment properties?
Our in-house team is constantly driving groundbreaking advancements in color innovation while adhering to strict performance and sustainability metrics.
Performance is key. While material and technical constraints can influence color feasibility, our ability to achieve such a broad algae-powered color palette is a testament to our innovations. Algaeing offers the widest algae-powered color palette available today—and we’re committed to expanding it even further, season after season.
By learning from nature and applying cutting-edge science, we continue to unlock new possibilities for cleaner, healthier colors for all.

In what ways do Algadye™ and Algaink™ support a circular economy? Can you elaborate on their role in enhancing textile recycling, biodegradability, or other innovative approaches to sustainable end-of-life solutions for dyed products?
We are committed to a fully circular approach—ensuring zero algae waste and making our products completely biodegradable. This is what makes our technology truly state-of-the-art.
As a ready-to-use, scalable solution, we empower manufacturers and brands to integrate clean, algae-powered colors into their textiles, reducing reliance on synthetic dyes and promoting a more sustainable production cycle.
At Algaeing, we see ourselves as more than just a product—we’re a platform for circular innovation. With ongoing breakthroughs in R&D, we continue to push the boundaries of sustainable color technology, leading the way toward a healthier, cleaner, and more circular textile industry.